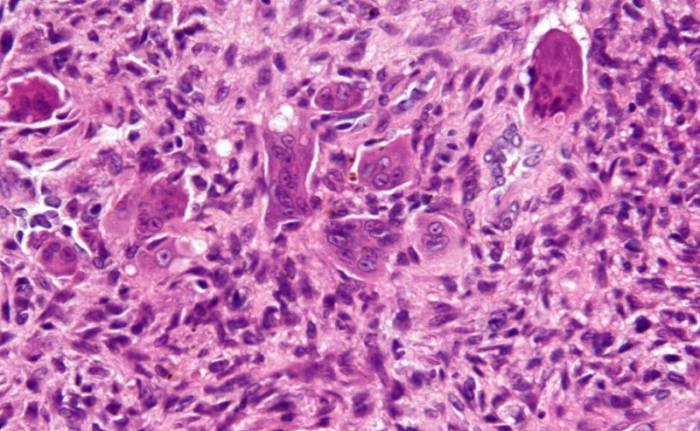
Эхинококк альвеолярный

Продолжительное время люди живут в мире вместе с паразитами и микроорганизмами. На протяжении многих тысячелетий продолжается эта гонка на выживание одних живых существ за счет других. Такое поведение называют паразитизмом, что таковым по сути своей и есть с биологической точки зрения.
Для многих гельминтов жизнь внутри другого живого существа – это длительные годы приспособления, скрывания своего присутствия и питания за чужой счет.

У большинства паразитарных заражений вовсе отсутствует симптоматика или она имеет размытую картину, напоминающую не один недуг.
Печень является излюбленным местом паразитирования многих гельминтов. В ней есть все, что для них жизненно необходимо – прекрасное кровоснабжение и огромное количество питательных материалов.
Какие паразиты живут в печени человека?
Активный обмен веществ в печени привлекает внимание многих паразитов. Одновременно с этим она практически беззащитна перед ними, что дает им возможность длительное время незаметно паразитировать и размножаться. Иногда черви в печени начинают свои активные действия, отчего у человека появляются разные негативные проявления.
Незавидное разнообразие червей, обитающих в печени заставляют людей задуматься и ужаснуться.
Врачи отмечают, что паразиты в печени человека могут вызывать разнообразные симптомы, включая боль в правом подреберье, желтуху, усталость и нарушения пищеварения. Эти проявления часто остаются незамеченными на ранних стадиях, что затрудняет диагностику. Специалисты подчеркивают важность своевременного обращения к врачу при подозрении на инфекцию. Для диагностики используются анализы крови, УЗИ и другие методы визуализации. Лечение обычно включает антигельминтные препараты, которые помогают избавиться от паразитов. Врачи также рекомендуют поддерживать иммунную систему и следить за гигиеной, чтобы снизить риск повторного заражения. Профилактика играет ключевую роль в борьбе с паразитарными инфекциями.
https://youtube.com/watch?v=IfDSDDJO0Wg
Амебы

Данные паразиты занимают одно из первых мест в этом списке. К человеку они попадают через фекально-оральные пути. Чтобы попасть в печень амебам необходимо пройти длинный путь через кишечник, кровеносные сосуды и лимфатическую систему. Присутствие этих червей в печени вызывает появление тромбов, негативно влияющих на питание клеток. Но диагностировать при этом их довольно нелегко так, как в частых случаях симптоматика похожа с гепатитом и другими недугами печени.
Все эти негативные процессы и отходы жизнедеятельности гельминтов ведут к появлению в органе некрозов, а последствии к амебному абсцессу.
Возникает воспаление вокруг места поражения и нагноение абсцесса.

Амебиаз сопровождается:
Лямблии

Эти паразиты очень сильно поражают печень, им в ней хорошо и комфортно. Зачастую они передаются посредством немытых рук. Могут продолжительное время находиться в почве в ожидании своего хозяина. От присутствия лямблий в печени, ее состояние существенно меняется, что требует незамедлительного лечения. Хотя тяжелых недугов печени они не провоцируют. Присутствие лямблий в печени проявляется такими признаками:
Паразиты в печени человека вызывают множество обсуждений среди медиков и пациентов. Симптомы, как правило, включают усталость, боли в правом подреберье, желтуху и расстройства пищеварения. Многие люди отмечают, что эти признаки могут быть неявными и проявляться постепенно, что затрудняет диагностику. Лечение паразитарных инфекций обычно включает антипаразитарные препараты, такие как мебендазол или альбендазол, однако важно также учитывать индивидуальные особенности пациента. Врачи подчеркивают важность профилактики, включая соблюдение правил гигиены и осторожность при употреблении сырой пищи. Регулярные медицинские осмотры могут помочь выявить проблему на ранней стадии и избежать серьезных осложнений.
https://youtube.com/watch?v=ThsiIJR8TdM
Шистосомы

По-другому их еще называют кровяными сосальщиками. Предпочитают обосновываться в печеночных кровеносных сосудах, чем провоцируют серьезные недуги. Заражение может настигнуть во время купания в пресном водоеме. Нередко можно наблюдать яйца в тканях печени. Поражение органа шистосомами может вызвать:
Эхинококк альвеолярный
Этот гельминт поражает печень на уровне тканей и клеток, походит из цестод. С его присутствием возникают:
Эхинококк однокамерный

Так же, как и эхинококк альвеолярный относится к цестодам. По своей внешности этот паразит подобен большому пузырю, постоянно растущему и увеличивающемуся в размерах. От роста этого «пузыря» наблюдается:
Аскариды

Эти паразиты являются круглыми червями. Их появление в печени сопровождается:
Аскариды провоцируют гнойный воспалительный процесс.
Симптомы гельминтов в печени

Появление червей в теле людей на ранних стадиях в основном проходит без особой симптоматики. Именно поэтому визит в больницу откладывается, глисты приумножаются, а болезнь прогрессирует.
Появление червей в печени сопровождается следующими не специфическими признаками:
Для каждого червя присутствующего в печени характерна своя индивидуальная симптоматика.

Амебиаз проявляется следующими признаками:
Лямблии изначально не проявляют себя никак.
Позже замечается:

Шистосомы характерны:
Эхинококкоз проявляет себя:
Аскаридоз имеет следующие симптомы:

Самыми выраженными для гельминтоза признаками считаются:
Черви, которые вызывают все эти симптомы могут причинить много хлопот человеку. Некоторые из них могут достигнуть до 25 см. Вместе со своим ростом они нуждаются в обильной еде, поедают не только полезные микроэлементы, но и ткани органа.
Поэтому при первых признаках наличия паразитов следует не медлить и обратиться к врачу, который после диагностики, если гельминтоз подтвердится, назначит соответствующее эффективное лечение.
Диагностика

Благодаря современным методам диагностировать червей в печени можно без проблем. Благодаря многим иммунологическим реакциям можно выявить антигены и антитела в крови.
Для диагностики чаще всего применяются такие методы:
Лечение

При подтверждении диагноза глистной инвазии в печени не стоит впадать в панику. Своевременное лечение поможет избежать множественных проблем. Печень обладает поразительной способностью быстро восстанавливаться в короткие сроки.
Лечение должно быть под строгим наблюдением паразитолога. В его основу входит в первую очередь назначение антипаразитарных препаратов широкого спектра действия. Это может быть Метронидазол, Хингамин, Пирантел, Декарис. Препарат и дозировка подбираются специалистом.
Антигельминтная терапия в печени проводится в три этапа:
- Во время первого этапа пациентам назначаются сорбенты, с помощью которых можно избавить больных от токсических продуктов жизнедеятельности паразитов.
- Второй этап включает в себя прием противопаразитных медикаментов. Хорошо зарекомендовал себя в этом случае Метовит.
- На третьем этапе после изгнания глистов из организма он нуждается в восстановлении. В этом помогут препараты, содержащие полезные микроэлементы, поливитамины, железо и повышающие иммунитет.

Хорошо было бы изгонять глистов из печени не только медикаментозными методами, но и при помощи народной медицины, которая давно зарекомендовала себя и всегда дает положительные результаты.
Прекрасным помощником в этом могут быть очистительные клизмы из чеснока или отвар из полыни, пижмы, чистотела или зверобоя.
Избежать появление паразитов в печени в дальнейшем помогут соблюдения элементарных правил личной гигиены и прием в профилактических целях противопаразитных препаратов.
https://youtube.com/watch?v=b4ukPOnH-Yw
Вопрос-ответ
Как выглядят печеночные паразиты?
В печени паразитические черви часто выглядят как пиявки или сгустки крови. Они имеют пурпурно-серый цвет, длинные, плоские и овальные формы.
Как тело сигнализирует о разрушении печени?
– Проявления могут быть разные. К примеру, нередко первоначально отмечается дискомфорт, тяжесть в правом подреберье, тошнота, рвота, пропадает аппетит. Однако чаще всего человек обращается к врачу, когда вдруг замечает желтушность склер, кожного покрова, зуд.
Советы
СОВЕТ №1
Регулярно проходите медицинские обследования, особенно если вы живете в регионах с высоким риском заражения паразитами. Это поможет выявить проблему на ранней стадии и начать лечение.
СОВЕТ №2
Обратите внимание на свое питание. Избегайте употребления сырой или недостаточно обработанной пищи, особенно рыбы и мяса, так как они могут быть источником паразитов.
СОВЕТ №3
Поддерживайте высокий уровень гигиены. Мойте руки перед едой и после контакта с животными, а также тщательно очищайте овощи и фрукты перед употреблением.
СОВЕТ №4
Если у вас есть подозрения на наличие паразитов, не занимайтесь самолечением. Обратитесь к врачу для получения точного диагноза и назначения адекватного лечения.

